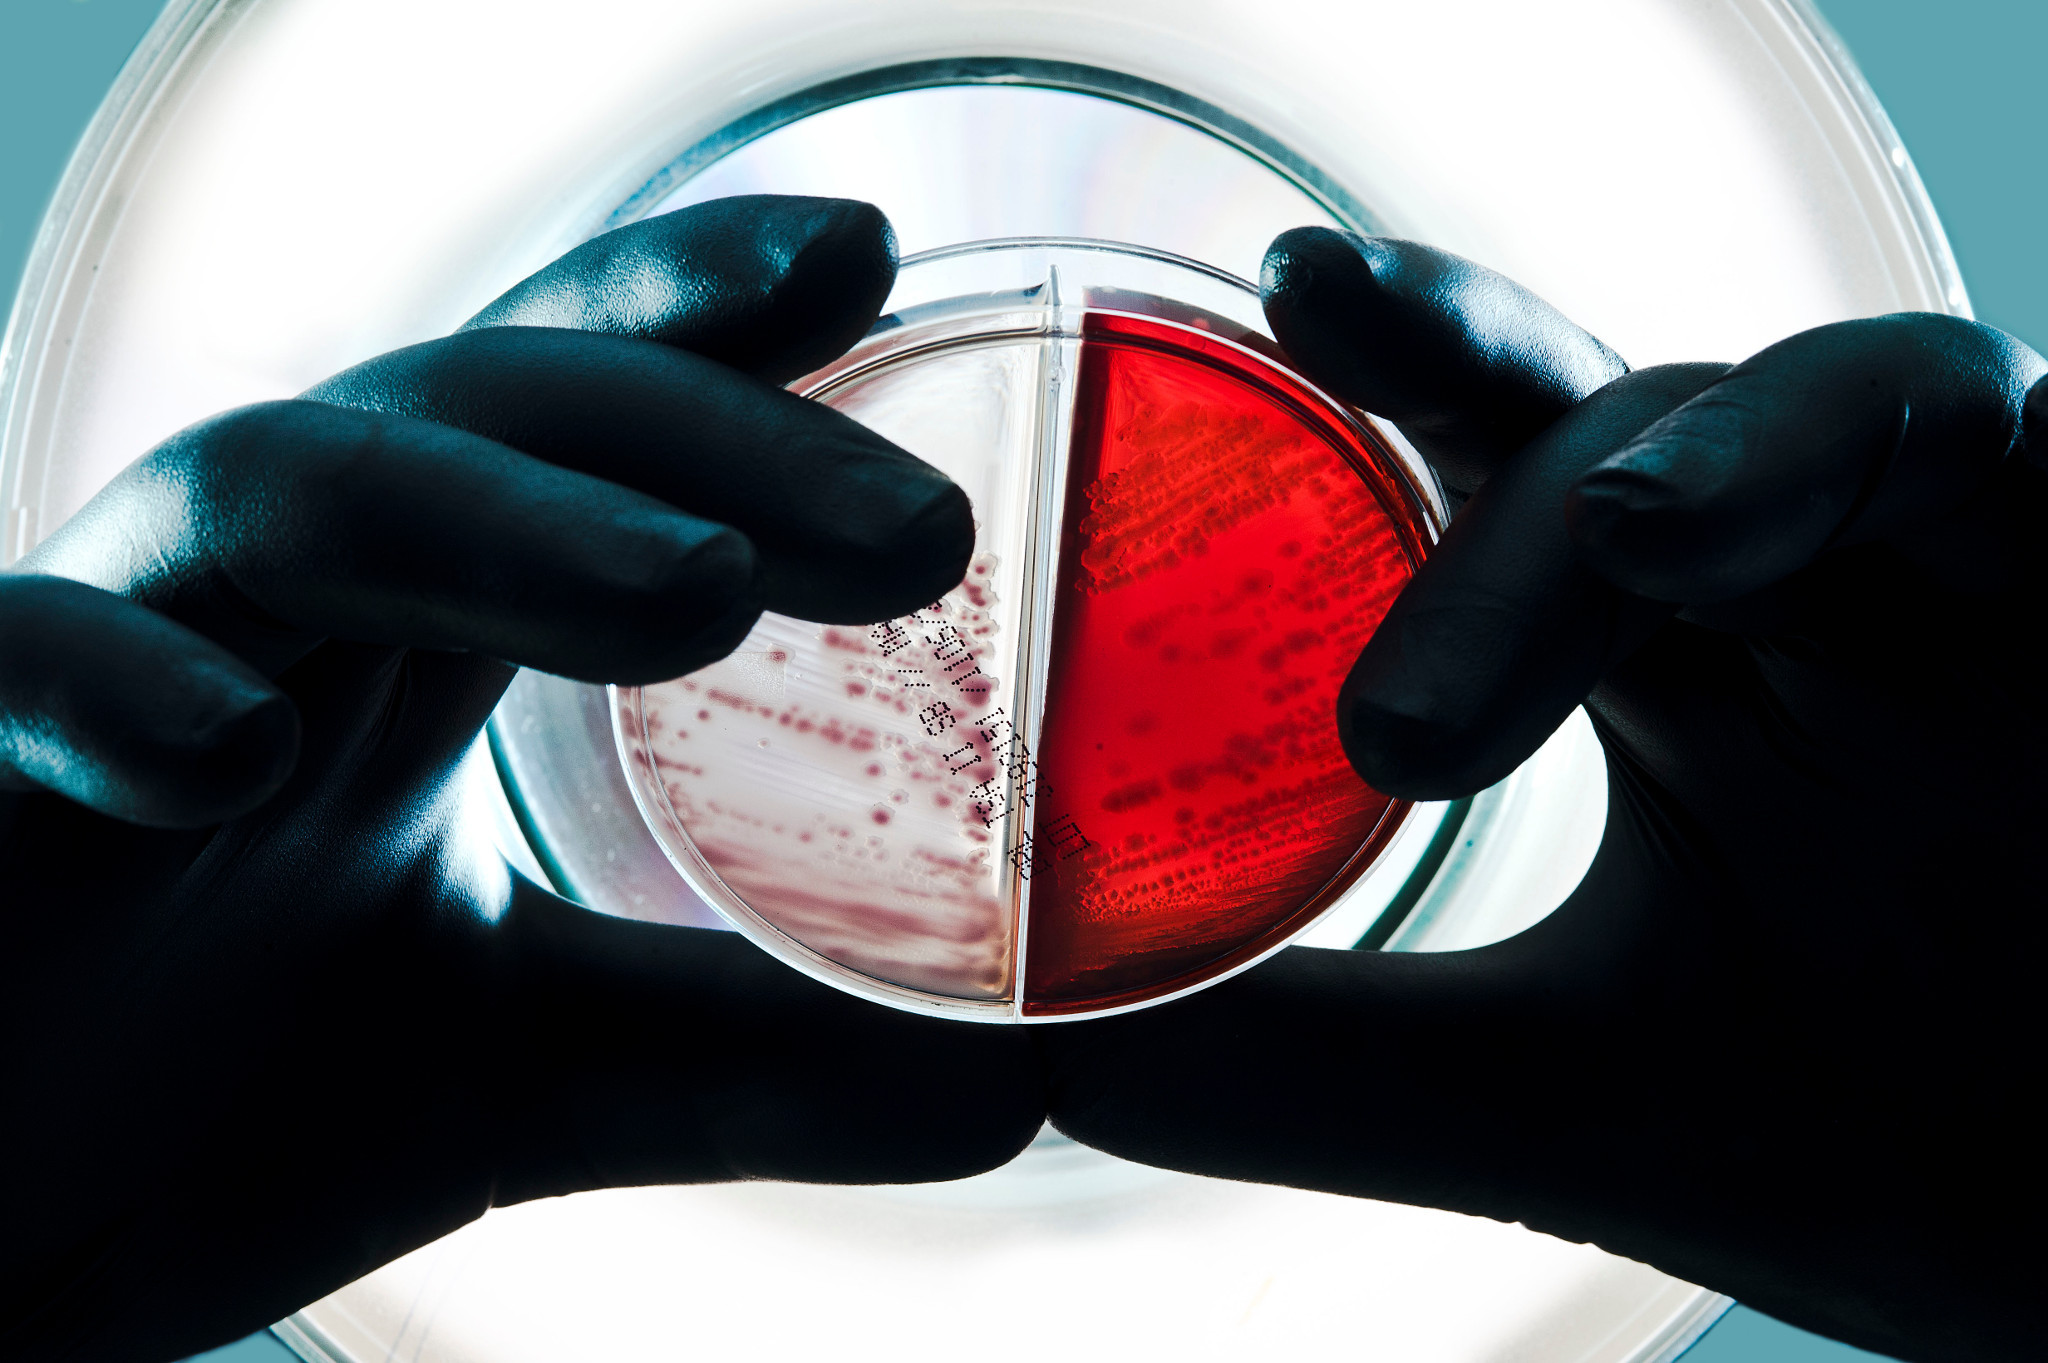
Wissenschaftler, der eine Probe betrachtet, um bei einem Reinigungs- oder Körperpflegeprodukttest herauszufinden, ob eine mikrobielle Kontamination vorliegt

Unser Fachwissen

Schnellnachweismethode von Mikroben
Celsis®-Systeme für den Schnellnachweis von Mikroben sparen Ihnen Zeit und Geld, weil Sie die Ergebnisse der Qualitätskontrolle in nur 24 Stunden vorliegen haben und so Produkte schneller freigeben können.
Korrekte mikrobielle Identifizierung
Accugenix®-Lösungen für die mikrobielle Identifizierung und Stammtypisierung sind korrekt, nachvollziehbar und reproduzierbar. Schließlich hängen Ihre operativen Entscheidungen davon ab.

Gesetzliche Qualitätsanforderungen in der Mikrobiologie
Alle gesetzlichen Bestimmungen für Ihr Produkt zu erfüllen, ist oft keine leichte Aufgabe. Unsere Experten beraten Sie gern dazu, was Sie zur Entwicklung und Marktfreigabe eines sicheren Produkts brauchen.

Sicherheitstests und Toxikologie für Kosmetika
Bevor ein Kosmetikprodukt freigegeben werden kann, muss es auf mögliche Nebenwirkungen untersucht werden. Wir testen für Sie einzelne Inhaltsstoffe, Mixturen und/oder Endprodukte mit einer In-vitro-Methode, die die Anforderungen für Körperpflege-Produkttests und Compliance erfüllt.
Intelligenter, Schneller, Besser
Erfahren Sie, wie wir gemeinsam mit Ihnen die Produktqualität gewährleisten und Sie mit schnelleren Testergebnissen unterstützen können, damit Ihre Produkte in kürzerer Zeit als zuvor die Marktfreigabe erhalten.
Broschüre herunterladen

-
Is it possible to reduce micro testing results to 24 hours?
Personal care product testing for microbial contamination is a critical step in assuring your products are free of unwanted bacteria, yeast, and mold. Today’s rapid screening systems provide accurate results on a broad range of product types in as few as 24 hours, trimming days from the average production cycle and mitigating risk in your supply chain. These alternative methods are validated and accepted by regulators on a global scale.
-
How can you improve QC lab efficiency and positively impact the overall production cycle?
When looking at adopting technology to streamline the supply chain, consider implementing a Celsis rapid microbial detection method that significantly reduces time to results without sacrificing quality. Product release approvals can be made with confidence, contamination remediated faster and more effectively, and timelines shortened, which impacts the company both operationally and financially.
-
Is there a single platform to test a majority of your product portfolio?
With an unmatched sample compatibility profile and application range, Celsis is your one stop solution for microbial detection with a single platform to test a majority of your product portfolio including standard products and over-the-counter drug products. Celsis can perform home, cosmetic, and personal care product testing with high or low viscosity, high or low pH, alcohol or water-based, pigmented, and preserved.
-
How can you take complete control of your ID data?
The Accugenix® Customer Web Portal includes a robust Tracking and Trending solution for all Accugenix identifications with customizable features for data entry and reports. Accugenix customers can sort and filter specific organisms, analyze frequency of occurrence, review Gram reaction, and more with the highest level of data encryption, system redundancies, and firewall protection which ensures 21 CFR Part 11 compliance.
-
Is it possible to harmonize your ID program across all your global sites?
Most of our global customers seek to ensure comparability of ID results across their sites and underestimate the difficulties of implementing a uniform approach. Our centralized reference library is used for identification ensuring trending and comparability of ID results across sites.
-
Is there specific guidance for cosmetic product testing?
The SCCS provides guidance on testing that may need to be performed (SCCS/1564/15) for all substances intended to be incorporated in a cosmetic product. Charles River scientists have been involved in the shaping of many of these cosmetic product tests; e.g., advising on the skin penetration guidance (SCCS/1358/10), and supporting the validation of new assays, e.g. HCE ocular irritation.